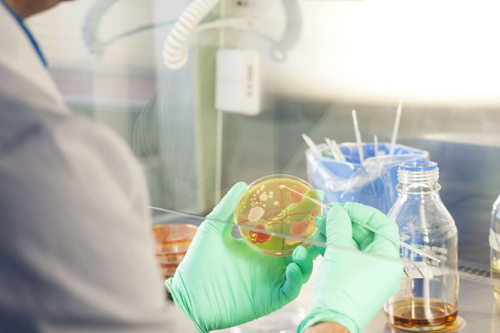

CONTACT US
HONG KONG OFFICE
East West International Trading Ltd.
FLAT B01, 2/F, KIN TAK FUNG INDUSTRIAL BUILDING, 174 WAI YIP STREET, KWUN TONG, HONG KONG
E-MAIL ID: hk@east-west-group.com
Contact: +(852) 6218 2717
MONTENEGRO OFFICE:
Representative Office in Montenegro
Bulevar Dzordza Vasingtona 98, Podgorica, Montenegro 81000
E-MAIL ID: info@east-west-group.com
Contact: +(382) 6851 6328